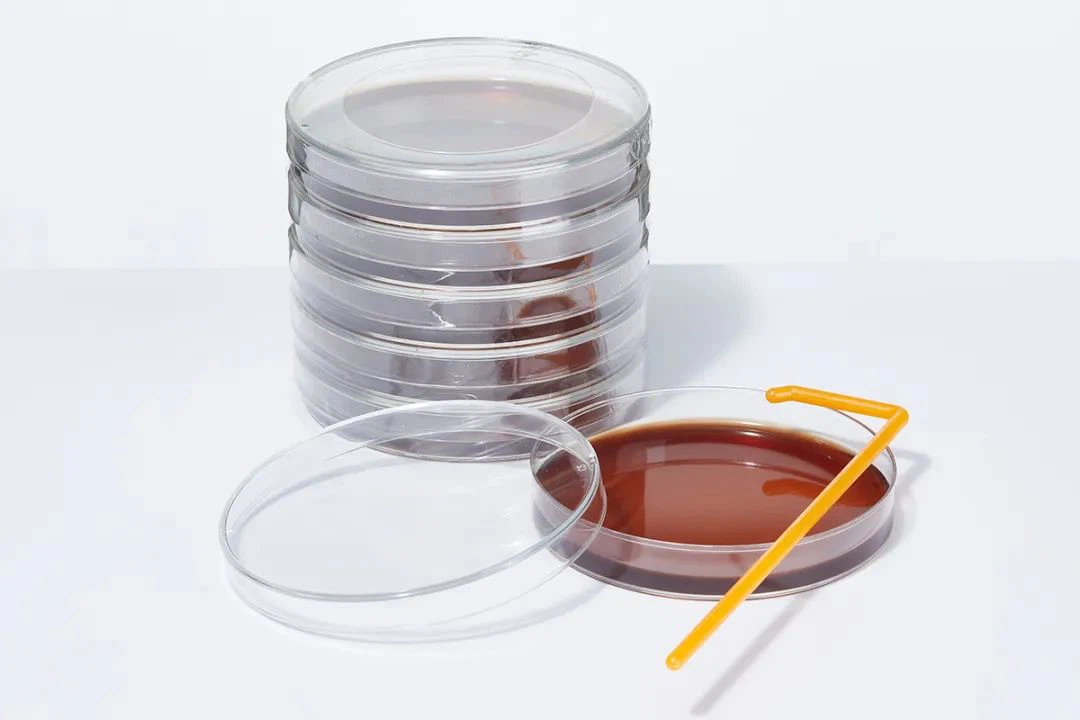
2

Evo nekih uobičajenih medija u eksperimentima
1. Nutritivni agar podloga za kulturu
Nutritivni agar podloga za kulturu se koristi za reprodukciju i kultivaciju običnih bakterija za mjerenje ukupnog broja bakterija, skladištenje bakterija i čiste kulture. Glavni sastojci su: potapanje govedine, ekstrakcija kvasca, proteini, natrijum hlorid, agar u prahu, destilovana voda. Proteini i goveđi prah obezbeđuju izvore azota, vitamina, aminokiselina i ugljenika. Natrijum hlorid može održavati uravnotežen osmotski pritisak. Jer agar je medij medijuma.
Nutritivni agar je najosnovnija vrsta podloge, koja sadrži hranjive sastojke potrebne za rast većine mikroorganizama. Nutritivni agar se može koristiti tokom konvencionalne bakterijske kulture.

2. Podloga za kulturu krvnog agara
Podloga za kulturu krvnog agara je podloga od proteina kašmira od goveđe paste koja sadrži dehidriranu životinjsku krv (obično krv zeca ili ovčiju krv). Stoga, osim uzgoja različitih nutrijenata potrebnih za bakterije, može osigurati i koenzime (kao što je V faktor), kao što je V faktor). Posebni faktori rasta kao što je hem (X faktor). Stoga se krvni medij često koristi za uzgoj, odvajanje i očuvanje određenih patogenih mikroorganizama koji zahtijevaju oštru ishranu.
Osim toga, krvni agar se obično koristi za test hemolize. U procesu rasta, neke bakterije mogu proizvesti hemolitin, koji može razbiti crvena krvna zrnca i otopiti se. Kada raste na pločici, oko kolonija se može uočiti proziran ili proziran hemolitički prsten. Patogenost mnogih bakterija povezana je s hemolitičkim karakteristikama. Zbog različitog hemolitina koji proizvode različite bakterije, hemolitička sposobnost je različita, a hemolitička pojava na trombocitima je različita. Stoga se hemolitički test često koristi za identifikaciju bakterija.
3. TCBS medijum
TCBS je sumpor sulfat citrat limunska kiselina sol sol sol sol saharoza agarmerin. Za selektivno odvajanje patogenih bakterija. Proteinske kukuljice, molikment kvasca u mediju kao osnovni nutrijenti za obezbjeđivanje različitih faktora rasta kao što su dušik, izvori ugljika i vitamini potrebni za rast bakterija; veća koncentracija natrijum hlorida kako bi se zadovoljila potreba za rastom soli u soli piramide; saharoza; saharoza; saharoza Kao fermentirani izvor ugljika; postojanje natrijum citrata, alkalne sredine visokog pH i natrijum sulfata inhibiraju rast crevnih bakterija, a natrijum u prahu žučne kese i natrijum goveđi galat uglavnom inhibiraju rast gram-pozitivnih bakterija.
Pored toga, natrijum sulfat takođe obezbeđuje sumpor kiseli sumpor. U uslovima citratnog gvožđa može se detektovati bakterijski vodonik sulfid. Ako postoje bakterije koje proizvodi sumporovodik, na tableti će se stvoriti crni talog. Tulifenol plavo i timfenol plavo. Ova dva jedinjenja su pH indikatori. Krobenol plava je pH indikator, a raspon promjene pH boje je 3,8 (žuta) ~ 5,4 (plavo-zelena). Postoje dvije vrste raspona promjene boje: (1) Kiselinsko područje je pH1.2 - 2.8, i crveno od žuto; (2) opseg alkalija je 8.0 do 9,6, od žute do plave.

4. TSA pankreasa soja agar podloga za kulturu
TSA sastojci su otprilike slični nutritivnom agaru. U nacionalnom standardu obično se koristi za ispitivanje testa prostorije za čišćenje (okrug) farmaceutske industrije. Odaberite ispitnu tačku u području koje želite testirati, otvorite TSA tablet i rasporedite ga na ispitnoj tački. Izlaganje na zraku duže od 30 minuta i ne čekati uzorkovanje, a potom kultivirati kolonije. Različiti nivoi čistoće zahtevaju različite kolonije.

5. Mueller-Hinton agar
MH medij je mikrobna podloga koja se koristi za otkrivanje mikroorganizama na otpornost na antibiotike. To je selektivan medij i većina mikroorganizama može rasti na njemu. Osim toga, škrob u sastojcima može apsorbirati toksine koje oslobađaju bakterije, tako da neće utjecati na rezultate antibiotskih operacija. Sastojci grupe MH kulture su labaviji, što pogoduje difuziji antibiotika, tako da može pokazati očigledne trake inhibicije rasta.
U kineskoj zdravstvenoj industriji, MH medij se također koristi za medicinsko testiranje. Prilikom provođenja nekih posebnih bakterija za medicinsko testiranje, kao što su bakterije upale pluća, 5 posto ovčje krvi i NAD mogu se dodati u podlogu kako bi se zadovoljile različite nutritivne potrebe.

6.SS agar
SS agar se obično koristi kao Salmonella, kultura selektivnog odvajanja Takagacia. Inhibiraju gram-pozitivne bakterije i većinu flore debelog crijeva i Transforima, ali ne utiču na rast salmonele; natrijum sulfat i željezni citrati se koriste za otkrivanje proizvodnje sumporovodika, čineći središte kolonija crnim; neutralna crvena; neutralna crvena; neutralna crvena; neutralna crvena; neutralna crvena; neutralna crvena; neutralna crvena; Za pH indikator, kolonije fermentiranog šećera su crvene, a kolonije nefermentiranog šećera su bezbojne. Salmonela je bezbojne prozirne kolonije ili crni centri, a Toroshishae su bezbojne i prozirne kolonije.

BKMAM snabdevanje:
Petrijeva posuda
Petlja za inokulaciju
Ploča za ćelijsku kulturu
Tikvica ćelijske kulture
I drugi laboratorijski potrošni materijal, dobrodošli, konsultujte nas za više detalja:






